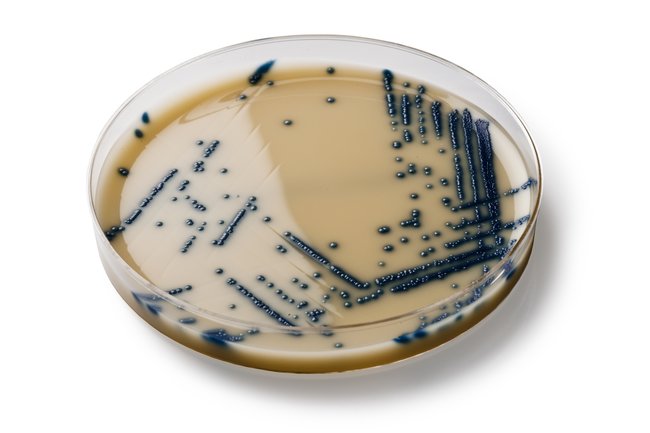

Spectra™ Vre Medium, Pack Of 10
$ 217.35
|
|
Details:
Obtain fast and accurate results with a chromogenic medium designed for screening clinical samples for the presence of vancomycin-resistant Enterococcus (VRE).
Additional Information
| SKU | 10159342 |
|---|---|
| UOM | Pack of 10 |
| UNSPSC | 41171608 |
| Manufacturer Part Number | R01830 |
